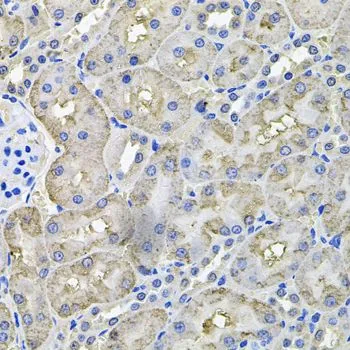

IHC-P analysis of human prostate tissue using GTX64472 Aconitase 1 antibody. Dilution : 1:100
Aconitase 1 antibody
GTX64472
ApplicationsImmunoHistoChemistry, ImmunoHistoChemistry Paraffin
Product group Antibodies
TargetACO1
Overview
- SupplierGeneTex
- Product NameAconitase 1 antibody
- Delivery Days Customer9
- Application Supplier NoteIHC-P: 1:50 - 1:100. *Optimal dilutions/concentrations should be determined by the researcher.Not tested in other applications.
- ApplicationsImmunoHistoChemistry, ImmunoHistoChemistry Paraffin
- CertificationResearch Use Only
- ClonalityPolyclonal
- ConjugateUnconjugated
- Gene ID48
- Target nameACO1
- Target descriptionaconitase 1
- Target synonymsACONS, HEL60, IREB1, IREBP, IREBP1, IRP1, cytoplasmic aconitate hydratase, aconitase 1, soluble, aconitate hydratase, cytoplasmic, citrate hydro-lyase, cytoplasmic aconitase, cytosplasmic aconitase, epididymis luminal protein 60, epididymis secretory sperm binding protein, ferritin repressor protein, iron regulatory protein 1, iron-responsive element-binding protein 1, soluble aconitase
- HostRabbit
- IsotypeIgG
- Protein IDP21399
- Protein NameCytoplasmic aconitate hydratase
- Scientific DescriptionThe protein encoded by this gene is a bifunctional, cytosolic protein that functions as an essential enzyme in the TCA cycle and interacts with mRNA to control the levels of iron inside cells. When cellular iron levels are high, this protein binds to a 4Fe-4S cluster and functions as an aconitase. Aconitases are iron-sulfur proteins that function to catalyze the conversion of citrate to isocitrate. When cellular iron levels are low, the protein binds to iron-responsive elements (IREs), which are stem-loop structures found in the 5 UTR of ferritin mRNA, and in the 3 UTR of transferrin receptor mRNA. When the protein binds to IRE, it results in repression of translation of ferritin mRNA, and inhibition of degradation of the otherwise rapidly degraded transferrin receptor mRNA. The encoded protein has been identified as a moonlighting protein based on its ability to perform mechanistically distinct functions. Alternative splicing results in multiple transcript variants [provided by RefSeq, Jan 2014]
- Storage Instruction-20°C or -80°C,2°C to 8°C
- UNSPSC12352203